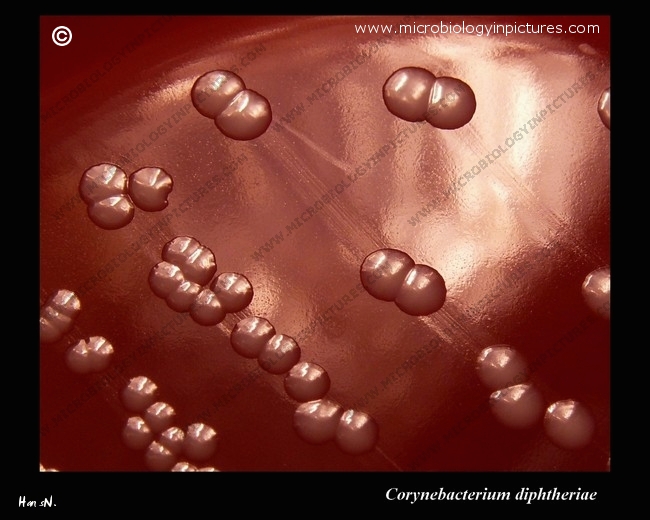

Brevibacterium
В молодых культурах палочки неправильной формы, 0,6 - 1,2 Х 1,5 - 6 мкм, одиночные или в парах, часто расположенные V-образно. Может встречаться ветвление, но мицелий не образуется. В старых культурах палочки распадаются на мелкие кокки. Грамположительные, но легко обесцвечиваются, неподвижные, неспорообразующие. Облигатные аэробы, хемоорганотрофы. Из глюкозы и других углеводов кислоту не образуют, или образуют в небольшом количестве. Каталазоположительные, как правило гидролизуют казеин и желатин. Колонии могут быть жёлто-оранжевыми или пурпурными.
Вот здесь оранжевые колонии - это они:
Фотографий пурпурных колоний нет. А жалко, потому что в иле довольно регулярно попадается нечто такое, чему вполне подходит эпитет "пурпурный", а в последнее время в одной секции почему-то появилось большое количество розовых и оранжево-красных хлопьев (так они всегда бурые).
Отдельные бактерии:
В интернете бревибактерии фигурируют в основном в связи с производством сыра и, я извиняюсь, вонючими ногами. Про последнее малоприятное обстоятельство я бы не упоминала, если бы не хотела продемонстрировать возможности народной микробиологии. У нас одна сотрудница рассказывала про своего родственника, который не ест сыр, потому что считает, что он воняет грязными носками. Выходит, это правда, а не результат нездоровых ассоциаций данного эксцентричного товарища.
Окисляют парафины, нафтены, фенолы, альдегиды, жирные кислоты.
Окисление пропана через ацетон с дальнейшей атакой на терминальный метил и декарбоксилированием:
CH3CH2CH3 → CH3CHOHCH3 → CH3CОСН3 → СН3СОСН2ОН → СН3СООН
О виде Brevibacterium ammoniilyticum пишут, что он "разрушает аммиак". Каким образом он это делает, непонятно (в смысле, ничего об этом не пишут). Выделен из ила очистных сооружений, растёт на средах, содержащих метанол и аммиак.
У него есть антипод Brevibacterium ammoniagenes. Он гидролизует мочевину до углекислоты и аммиака, восстанавливает нитраты до нитритов, желатин, казеин, хитин, целлюлозу, крахмал и ксантин не гидролизует. Факультативный анаэроб (в определителе, из которого я брала общую характеристику рода, этого вида нет).
Cellulomonas
В молодых культурах тонкие палочки неправильной формы 0,5 - 0,6 Х 2 - 5 мкм, прямые или слегка изогнутые, некоторые в парах V-образной конфигурации, иногда палочки ветвятся, но мицелий не образуют. В старых культурах палочки короткие и могут присутствовать немногочисленные кокки. Грамположительные, но легко обесцвечиваются. Часто подвижные за счёт одного или нескольких жгутиков. Неспорообразующие. При росте на агаризованной среде с пептоном и дрожжевым экстрактом образуют выпуклые жёлтые колонии. Хемоорганотрофы, обладающие и дыхательным, и бродильным типами метаболизма с образованием кислоты из глюкозы и различных других углеводов в аэробных и анаэробных условиях. Восстанавливают нитрат до нитрита. Широко распространены в почве и гниющих овощах.

Как и положено бактериям с таким названием, Cellulomonas занимается разложением целлюлозы, как в аэробных, так и в анаэробных условиях. Разложение целлюлозы состоит из нескольких этапов. Сначала разрываются гликозидные связи внутри целлюлозной цепочки, что приводит к образованию довольно крупных фрагментов со свободными концами. Потом от конца цепочки отщепляется дисахарид целлобиоза, которая затем гидролизуется до глюкозы.
На что они ещё способны - не знаю.
Corynebacterium
Прямые или слегка изогнутые тонкие палочки с заострёнными или иногда булавовидными концами, 0,3 - 0,8 Х 1,5 - 8 мкм, клетки вида C. matruchotii имеют кнутовидную форму. Как правило, одиночные или в парах, часто V-образной конфигурации, или в стопках из нескольких параллельно лежащих клеток. Грамположительные, хотя некоторые клетки окрашиваются неравномерно (в виде чёток). Внутри клеток, как правило, образуются метахроматиновые гранулы полиметафосфата. Неподвижные, неспорообразующие. Колонии выпуклые, полупрозрачные, с матовой поверхностью. Хемоорганотрофы; факультативные анаэробы; метаболизм бродильного типа.
Стоит обратить внимание, что там, где я беру свой список бактерий, коринебактерии названы "углеродокисляющими", а они, выходит, ничего не окисляют. Сначала я решила, что в данном контексте это не очень большой грех - автор просто не смог придумать более подходящее слово для обозначения бактерий, потребляющих органику, но следующим в списке идёт Desulfotomaculum, а это уже возмутительно, так как он строгий анаэроб и никак не может входить в состав хлопьев активного ила. В общем, сомнительный у меня источник, но других почти нет.
Большинство видов образуют из глюкозы и некоторых других углеводов кислоту без газа. Каталазоположительные; часто восстанавливают нитрат и теллурит. В редких случаях образуют кислоту из лактозы или разжижают желатин. Большиство облигатные паразиты на слизистых оболочках и кожных покровах млекопитающих. Наиболее известный среди них вид - возбудитель дифтерии C. diphtheriae. Есть сведения о переработке коринебактериями углеводородов, но без подробностей. Список видов коринебактерий.
Corynebacterium tuberculostearicum:
Такие жизнерадостные коринебактерии получаются в результате применения просвечивающего электронного микроскопа и приёма под названием "False-colour" - насколько я смогла понять, каким-то параметрам объекта, не имеющим отношения к длине волны, например плотности, волевым решением присваиваются те или иные цвета:

Bacterium
В одном из старых руководств по гидробиологическому контролю работы очистных сооружений этот род указывается в числе трёх наиболее распространённых в активном иле. Плохо только то, что с тех пор его, судя по всему, расформировали. По крайней мере в определителе его нет, да и в остальном интернете общую характеристику с трудом удалось найти.
Там пишут: "Представлен организмами с грамотрицательными мелкими палочковидными клетками с перитрихиальным жгутикованием. Одной из наиболее изученных бактерий рода Bacterium является кишечная палочка Bacterium coli (в ряде определителей описывается под другим названием — Escherichia coli)." Однако, в более "молодых", чем тот определитель, источниках этот род встречается. В общем, дело тёмное, ну и ладно.
К этому роду относятся три бактерии с красноречивыми названиями Bacterium aliphaticum, Bacterium benzolicum и Bacterium toluolicum. Первый усваивает алифатические углеводороды от С6 до С24, метанол, бутаол, фенол, уксусную и муравьиные кислоты и альдегиды. Не усваивает ароматические углеводороды. Про остальные не пишут. Bacterium formicum демонстрирует наиболее простой способ сбраживания органических кислот, она получает энергию при расщеплении муравьиной кислоты на углекислый газ и водород.
Кишечной палочке тоже надо уделить пару слов, а то вдруг авторы того руководства именно её и имели в виду. Хотя я в этой палочке разочаровалась. Наши засланцы, периодически отправляемые в дружественную баклабораторию на время отпусков и больничных тамошних работников, рассказывали, что колонии кишечной палочки имеют в той или иной степени красный цвет. А разноцветные бактерии - это не только красиво, но и удобно с точки зрения определения вида. Оказывается, колонии у них бесцветные и вообще невзрачные:
А красными они становятся из-за выращивания на среде, содержащей фуксин. Кроме фуксина она содержит лактозу и сульфит натрия (среда Эндо). Фуксин взаимодействует с сульфитом натрия и образует бесцветную фуксинсернистую кислоту. В процессе сбраживания бактериями лактозы образуется муравьиная кислота, которая превращает фуксинсернистую кислоту обратно в фуксин.
Это факультативный анаэроб с метаболизмом и дыхательного, и бродильного типа. Мочевину и липиды не гидролизует. Восстанавливает нитраты. Все или большинство представителей рода Escherichia браживают L-арабинозу, D-ксилозу, мальтозу, D-маннитол, D-маннозу, L-рамнозу и трегалозу. Отмечена в качестве разрушителя нефтепродуктов.
Размер палочек 0,4—0,8 х 1—3 мкм, есть штаммы подвижные, со жгутиками и неподвижные, без жгутиков:
Многие подходят к изображению кишечной палочки творчески: